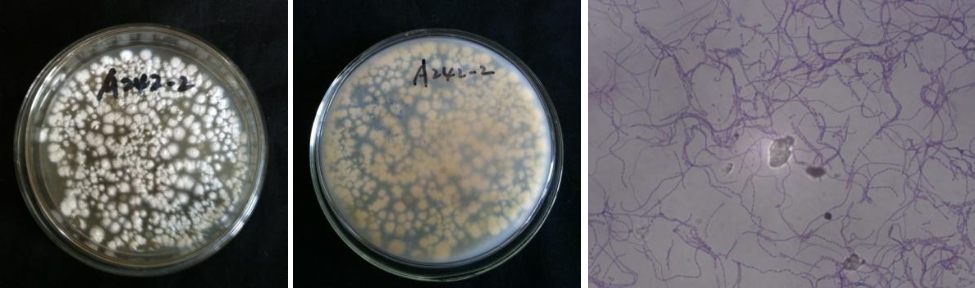

Loading...
| StrainNO | A242 |
| Classification | Amycolatopsis |
| 16s rDNA sequence | TCGCATGGGGGTTGGTTGAAAGTTTCGGCGGTRCAGGATGAGCCCGCGGCCTATCAGCTTGTTGGTGGGGTGATGGCCTACCAAG GCGACGACGGGTAGCCGGCCTGAGAGGGTGACCGGCCACACTGGGACTGAGACACGGCCCAGACTCCTACGGGAGGCAGCAGTGG GGAATATTGCACAATGGGCGGAAGCCTGATGCAGCGACGCCGCGTGAGGGATGACGGCCTTCGGGTTGTAAACCTCTTTCGCCAG GGACGAAGCGCAAGTGACGGTACCTGGATAAGAAGCACCGGCTAACTACGTGCCAGCAGCCGCGGTAATACGTAGGGTGCGAGCG TTGTCCGGATTTATTGGGCGTAAAGAGCTCGTAGGCGGTTTGTCGCGTCGTTCGTGAAAACTCCACGCTTAACGTGGAGCGTGCG GGCGATACGGGCAGACTTGAGTTCGGTAGGGGAGACTGGAATTCCTGGTGTAGCGGTGAAATGCGCAGATATCAGGAGGAACACC GGTGGCGAAGGCGGGTCTCTGGGCCGATACTGACGCTGAGGAGCGAAAGCGTGGGGAGCGAACAGGATTAGATACCCTGGTAGTC CACGCTGTAAACGTTGGGCGCTAGGTGTGGGTGACATTCCACGTTGTCCGTGCCGTAGCTAACGCATTAAGCGCCCCGCCTGGGG AGTACGGCCGCAAGGCTAAAACTCAAAGGAATTGACGGGGGCCCGCACAAGCGGCGGAGCATGTGGATTAATTCGATGCAACGCG AAGAACCTTACCTGGGCTTGACATGCACTGGAAACCAGTAGAGATATTGGCCCCCTTGTGGCCGGTGTACAGGTGGTGCATGGCT GTCGTCAGCTCGTGTCGTGAGATGTTGGGTTAAGTCCCGCAACGAGCGCAACCCTTATCCTACGTTGCCAGCAAGTAAAGTTGGG GACTCGTGGGAGACTGCCGGGGTCAACTCGGAGGAAGGTGGGGATGACGTCAAGTCATCATGCCCCTTATGTCCAGGGCTTCACA CATGCTACAATGGCTGGTACAGAGGGCTGCGATACCGCGAGGTGGAGCGAATCCCTTAAAGCCGGTCTCAGTTCGGATCGCAGTC TGCAACTCGACTGCGTGAAGTCGGAGTCGCTAGTAATCGCAGATCAGCAACGCTGCGGTGAATACGTTCCCGGGCCTTGTACACA CCGCCCGTCACGTCATGAAAGT |
| Strain Morphology Photos | |
| Morphological Description | Hyphae branches;septa unfractured spore filaments curved or straight;broken into barrel-shaped spore piles almost bare;few white spore piles;translucent |